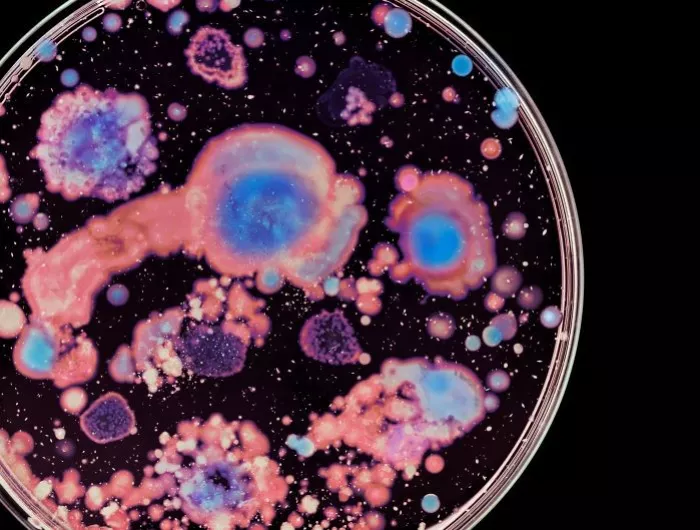

Clinical example
Impaired colonisation resistance has been linked to greater susceptibility to post-infectious IBS following gastroenteritis, with some individuals experiencing long-term symptoms after an acute infection. 9,10
Microbial diversity is the first line of defence against pathogens
In a diverse, well-balanced community, many species compete for space and nutrients, leaving few open niches for potential pathogens to occupy. Beneficial microbes also shape the gut environment to limit pathogen growth — producing acids and short-chain fatty acids that lower luminal pH, generating antimicrobial compounds, maintaining the mucus layer and priming host immunity. 5,6,7
When diversity is reduced — after antibiotics, severe illness or restrictive diets — this protective network can weaken. With fewer competitors and less functional redundancy, opportunistic organisms may gain a foothold.8

Diet determines what the microbiome produces
Fibre fermentation and health-supporting metabolites
What microbes do is strongly influenced by what they are fed. Many dietary fibres cannot be digested by human enzymes but can be fermented by gut microbes, producing short-chain fatty acids such as acetate, propionate and butyrate — metabolites that support barrier integrity, reduce inflammation and regulate metabolism.11,12
Critically, the gut microbiota is metabolically flexible. Microbes that produce beneficial metabolites from dietary fibre can shift towards less favourable outputs when the diet is low in fermentable carbohydrates and high in protein or fat. The type and diversity of fibre matter as much as total fibre intake.11
Microbial metabolites shape immune function across the lifespan
From birth, the immune system learns to distinguish between threats and harmless exposures. Early contact with diverse microbes supports the development of regulatory pathways that reduce the risk of over-reactive responses. Disruptions in early-life microbial exposure have been associated with increased risk of allergies, asthma, inflammatory bowel disease and autoimmune conditions.21,22,23
In adulthood, the microbiome continues to shape immune tone. SCFAs promote regulatory T cells, tryptophan-derived metabolites modulate innate immune responses, and bacterial cell wall components can trigger or dampen inflammatory signalling. When the microbiome is balanced, these signals usually support a steady, controlled immune state.14,24,25
Clinical example
In oncology, gut microbiome composition has been linked to better or worse responses to
immunotherapy, suggesting microbial immune modulation can influence treatment outcomes.27

Health outcomes depend on microbial cooperation
Cross-feeding and microbial cooperation
Many clinically relevant metabolites are not produced by a single microbe acting alone. Instead,
they arise through cross-feeding, where one species’ metabolic by-products become another
species’ fuel. This distributed architecture also explains how people with very different species
profiles can still display similar functional capacities.28

A community with a robust network of cooperative and competitive interactions tends to be more
stable and resilient in the face of disturbances such as illness, antibiotics or sudden dietary
changes.1

Functional potential only becomes
functional reality when the right conditions align
Modern sequencing technologies can estimate the microbiome’s functional potential by identifying
genes and pathways — a valuable starting point. However, this potential must be realised through
the right conditions, and especially fuel source availability.11
Because healthy people can have very different species profiles, it is difficult to define a single “ideal” microbiome based only on who is present. It is more practical to think in terms of functional balance: a state where activities that support health are robust, while pathways that generate potentially harmful metabolites are kept in check.34,35

This is why the same intervention — higher fibre intake, probiotics or medication — may help one person but worsen symptoms in another, depending on microbial functions, dietary context and host factors. Supporting health often means working with the ecosystem: providing the right fuels, avoiding unnecessary disruptions, and using targeted strategies to shift microbial functions rather than chasing individual species.31,32,33
Key Takeaway
The microbiome is a dynamic ecosystem whose functions, not just its composition — shape human health. Diverse communities support colonisation resistance, diet determines metabolic outputs, and health outcomes depend on community cooperation and functional balance rather than individual species.1,3
Functional potential only becomes functional reality when the right fuels and conditions align. A functional, ecosystem-based lens supports more personalised, targeted strategies to maintain or restore health.3,4

Microbial diversity is the first line of defence against pathogens
One of the most important ways the microbiome supports health is by helping protect against harmful microorganisms, a process called colonisation resistance. In a diverse, well-balanced community, many species compete for space and nutrients, leaving few open niches for potential pathogens to occupy. This competitive exclusion means that invaders struggle to find food or sites to attach and grow.
pH modulation
Production of acids and SCFAs lowers luminal pH, making the colon less hospitable for certain harmful bacteria.
Antimicrobial compounds
Generation of bacteriocins and other compounds that directly inhibit competitors.
Barrier maintenance
Support of the mucus layer and gut barrier, limiting pathogen and toxin access to the intestinal wall.
Immune priming
Promotion and priming of innate immune cells, enabling faster response to enteric infection.
When diversity is reduced — after antibiotics, severe illness or restrictive diets — this protective network can weaken. With fewer competitors and less functional redundancy (fewer microbes able to perform the same protective functions), opportunistic organisms may gain a foothold and, in some cases, establish infection or persistent colonisation.
Clinical example
Impaired colonisation resistance has been linked to greater susceptibility to post-infectious IBS following gastroenteritis, with some individuals experiencing long-term symptoms after an acute infection. 9,10

Diet determines what the microbiome produces
Fibre fermentation and health-supporting metabolites
What microbes do is strongly influenced by what they are fed. Many dietary fibres cannot be
digested by human enzymes but can be fermented by gut microbes. When bacteria ferment
complex carbohydrates, they can produce short-chain fatty acids such as acetate, propionate
and butyrate.11,12
Critically, the gut microbiota is metabolically flexible. Microbes that produce beneficial metabolites from dietary fibre can shift towards less favourable outputs when the diet is low in fermentable carbohydrates and high in protein or fat. Different fibres (resistant starch, inulin, arabinoxylans) favour different microbial groups and can shift SCFA profiles, so the type and diversity of fibre matter as much as total fibre intake.
Clinical example
Impaired colonisation resistance has been linked to greater susceptibility to post-infectious IBS following gastroenteritis, with some individuals experiencing long-term symptoms after an acute infection. 9,10

Microbial metabolites shape immune function across the lifespan
Early-life training.
From birth, the immune system learns to distinguish between threats and harmless exposures. Microbes are key teachers in this process. Early contact with a diverse set of microbes helps immune cells learn when to respond strongly and when to remain tolerant, supporting the development of regulatory pathways that reduce the risk of over-reactive responses.
Disruptions in early-life microbial exposure — frequent antibiotics, limited dietary diversity or lack of environmental microbial contact — have been associated with increased risk of allergies, asthma, inflammatory bowel disease and some autoimmune conditions later in life.
Ongoing immune modulation in adults
In adulthood, the microbiome continues to shape immune tone. Microbial products interact with pattern-recognition receptors and other immune sensors, sending signals that can either amplify or dampen inflammation.
When the microbiome is balanced, these signals usually support a steady, controlled immune state. When microbial composition and function are disrupted, signalling may become skewed in ways that can contribute to chronic inflammation in susceptible individuals.24
Clinical example
In oncology, gut microbiome composition has been linked to better or worse responses to
immunotherapy, suggesting microbial immune modulation can influence treatment outcomes.

Health outcomes depend on microbial cooperation
Cross-feeding and microbial cooperation
Many clinically relevant metabolites are not produced by a single microbe acting alone. Instead, they arise through cross-feeding, where one species’ metabolic by-products become another species’ fuel. For example, fibre fermentation by Bifidobacterium spp. can generate acetate and lactate that is then converted into butyrate by butyrate-producing Firmicutes such as Faecalibacterium prausnitzii, Roseburia and Eubacterium.28

This distributed architecture also helps explain how microbial communities become more stable and resilient to disturbances, and how people with very different species profiles can still display similar functional capacities: different microbial “teams” can lead to similar metabolic outcomes.
 |
 |
Functional potential only becomes
functional reality when the right conditions align
Modern sequencing technologies can estimate the microbiome’s functional potential by identifying genes and pathways — a valuable starting point. However, this potential must be realised through the right conditions, and especially fuel source availability.
What bacteria produce depends heavily on available substrates: when fermentable carbohydrates are plentiful, SCFA production often increases; but when dietary fibre is limited, proteolytic fermentation pathways can become more prominent.11

CLINICAL EXAMPLE
Individuals with higher butyrate-producing capacity may show greater response and metabolic benefit when diets provide matching fermentable fibres, illustrating how diet can “unlock” functional capacity.31,32,33

Health as a functional balance
Because healthy people can have very different species profiles, it is difficult to define a single "ideal" microbiome based only on who is present. It is more practical to think in terms of functional balance.34
Functional balance
Functional dysbiosis
A functional microbiome lens helps explain why the same intervention — higher fibre intake, probiotics or medication — may help one person but worsen symptoms in another, depending on microbial functions, dietary context and host factors. Supporting health often means working with the ecosystem: providing the right fuels, avoiding unnecessary disruptions, and using targeted strategies to shift microbial functions rather than chasing or eradicating individual species.

Key messages
Key POINT
The microbiome is a dynamic ecosystem whose functions — not just its composition — shape human health. Diverse communities support colonisation resistance, diet determines metabolic outputs, and health outcomes depend on community cooperation and functional balance rather than individual species.1,3

The gut microbiome is
a measurable biological system
The gut microbiome is fundamental to normal human physiology. It is a dynamic ecosystem that influences immune regulation, gut barrier integrity, metabolism, and systemic signalling.⁴
This is a two-way relationship. The microbiome contributes
to metabolic activity, produces bioactive compounds, and participates in immune signalling.
In turn, the body provides nutrients that support gut microbes
and influences how they behave. Diet, immune activity, and gut conditions all shape which microbes thrive and what they do.4,5
The microbiome is an integral biological system with meaningful implications for complex and multi-system presentations. Clinically, this is especially important for patients whose symptoms don’t fit neatly into a single diagnosis or one clear cause.

The gut microbiome is composed of diverse microbial communities
The gut microbiome is a diverse community of microorganisms that actively shape gut function through metabolism, competition, and interactions with the immune system and gut lining. This community includes:

Bacteria

Archaea

Viruses

Fungi
The healthy function of the microbiome depends on a balanced ecosystem
The role a microbe plays is not fixed, it depends on the gut environment and the overall ecological balance of the community. Host-microbe interactions generally fall into four broad categories: commensal, mutualistic, opportunistic and pathogenic. These categories are not rigid. The same organism can shift from mutualistic or commensal to opportunistic depending on changes in diet, immune status, or the surrounding microbial community.⁴
COMMENSAL
Present without clearly measurable benefit or harm to the host -- though as detection methods improve, truly neutral organisms are increasingly rare.
MUTUALISTIC
Contributes positively to metabolism, immune regulation, or barrier integrity.
OPPORTUNISTIC
Typically, harmless but may cause harm when ecological balance is disrupted, for example, after antibiotic use or during immune suppression.
PHATHOGENIC
Capable of causing disease or disrupting normal function.
Microbes convert fuel into compounds that influence health
Gut microbes feed on available substrates, including dietary fibre, proteins, and host-derived compounds, and convert them into metabolites that interact with body systems.4,6 Some of these metabolites act locally within the gut, influencing barrier integrity and immune signalling. Others enter the bloodstream and affect organs and processes throughout the body.
What is produced depends on:
Species: The microbes present
Functional pathways: The key metabolic functions they perform
Dominant substrates: The main fuel sources they utilise

This is why microbiome assessment increasingly focuses on functional capacity and metabolic output — not just species detection.
Knowing which microbes are present isn’t enough, you need to know what the ecosystem is doing.
Microbiome composition varies significantly between individuals. ⁷ While certain microbial groups are commonly found across populations, the relative abundance, diversity, and functional output differ from person to person.
This variability is shaped by many factors – including diet, medication use, genetics, environmental exposures, and lifestyle, all of which influence both microbial composition and metabolic capacity. ⁷
Two individuals can share similar broad microbial groups yet differ considerably in their specific species or strains,² and those species and strains may carry different genes with different metabolic capacities.8,9 The reverse is also true: two people with very different microbial profiles may share comparable functional outputs, because different species can produce the same metabolites.2,3,10
This is why microbiome assessment increasingly focuses on functional capacity and metabolic output – such as butyrate production or mucin degradation, rather than species detection alone.

The microbiome influences health through four key pathways
The gut microbiome influences health not by controlling organs directly, but through the metabolites it produces and the signals they generate.
While the microbiome's influence on the body is broad, four well-characterised functions are particularly relevant to clinical practice: metabolism, immune regulation, gut barrier integrity, and systemic signalling. Importantly, this relationship is bidirectional - the body's environment, including diet, immune activity, and gut conditions, also shapes the microbiome.
Metabolism
Microbial metabolites influence energy use, lipid processing and systemic metabolic balance.
Gut microbes act like a metabolic organ, producing thousands of different metabolites from dietary and host-derived compounds.11,12 Some of these metabolites stay in the gut, where they can affect inflammation, transit time, and the gut lining. Others cross into the bloodstream and can influence inflammation, energy balance, lipid processing, and metabolic regulation throughout the body.11,12
Immune regulation
Continuous exposure to microbial signals helps calibrate immune tolerance and responsiveness.
The microbiome continuously interacts with immune cells within the gut-associated lymphoid tissue (GALT).14 Microbial antigens and metabolites help calibrate immune responsiveness – supporting tolerance to harmless signals while maintaining the ability to respond to genuine threats. For example, some short-chain fatty acids promote the production of regulatory T cells that help prevent over-reactive inflammation.15,16 Rather than simply stimulating immunity, the microbiome plays a central role in immune homeostasis.14
Gut barrier function
Microbial activity supports epithelial integrity and regulated immune signalling.
The gut barrier is a set of layers that separates gut contents from the bloodstream: a mucus layer, a single layer of epithelial cells, and tight junctions between those cells. Microbial metabolites – including butyrate and some tryptophan-derived indoles, can strengthen this barrier by providing an energy source to gut cells and promoting tight junction integrity.6,13,17-19 Thus, barrier function is not purely structural, it is actively maintained by microbial metabolism.
Systemic signalling
Microbial compounds contribute to neuroimmune signalling involved in stress, inflammation, and metabolic integration.
Microbial metabolites interact with the body’s receptors and influence signalling pathways beyond the gut, including enteroendocrine signalling, neural circuits, and immune pathways.4,20 The gut and brain communicate through nerves (including the vagus nerve), hormones, and immune signals. Gut microbes can influence these pathways by producing or modifying neuroactive compounds and by modulating inflammation levels.20
The microbiome functions as part of human biology — not separate from it.
What shapes a person's gut microbiome
The gut microbiome is not static, it is continually adjusting to its environment. A range of modifiable and non-modifiable factors influence which microbes thrive and what they do, many of which are modifiable.⁷
Diet
Medications
Infections and inflammation
Lifestyle and environment
What happens when the microbiome is out of balance
There is no single "perfect" microbiome. Healthy people can have very different microbial profiles. However, when the balance shifts significantly, it can affect what the microbiome produces and how the body responds. An imbalanced microbiome — sometimes called dysbiosis — often involves one or more of the following:
Loss of helpful microbes (for example, fibre-fermenting short-chain fatty acid producers)
Overgrowth of potentially harmful microbes (sometimes called pathobionts)
Reduced diversity (fewer different types of microbes)
A shift in what the microbiome is doing — such as producing fewer protective molecules and more inflammatory molecules
How imbalances can affect the immune system and inflammation


Pro-inflammatory LPS (endotoxin)
Specific types of LPS (hexa-acylated or higher) are strong triggers for inflammation because they can activate a receptor on immune cells called TLR4, which can initiate an inflammatory cascade. Other types of LPS are weaker and may even help block this signalling. When the balance shifts toward bacteria that produce strongly inflammatory LPS, inflammatory signalling can increase. Increased levels of these bacteria have been observed in Crohn’s disease, rheumatoid arthritis, and ankylosing spondylitis.

Mucus layer damage when fibre is low
If dietary fibre is limited, some microbes can switch to using mucus as a fuel source. In animal studies, a fibre-deprived diet increased mucus-degrading bacteria, thinned the mucus barrier, and increased susceptibility to infection and inflammation. In humans, the relative abundance of mucin-degrading pathways has been positively correlated with faecal calprotectin, a clinical marker of inflammation in the gut.

Lower butyrate and IPA-producing species
Butyrate is a short-chain fatty acid that serves as the primary energy source for colon cells and plays a key role in immune regulation. Indole-propionic acid (IPA) is a tryptophan-derived metabolite also involved in immune regulation and maintaining intestinal barrier integrity. Reduced levels of butyrate-producing species and plasma IPA have been associated with inflammatory bowel diseases and type 2 diabetes.

Defending against pathogens
A diverse microbiome with adequate levels of butyrate producers can help prevent overgrowth of harmful microbes by competing for space and nutrients, producing antimicrobial substances, and maintaining key signalling pathways. When the microbiome is disrupted, for example after antibiotics, this protective function can be compromised, leaving people more susceptible to pathogen infections.
What matters most in clinical interpretation
Because the microbiome interacts with multiple biological systems, it can provide additional interpretive context in chronic and complex presentations, particularly when traditional markers do not fully explain a patient's symptoms.
The microbiome is not best understood through a "good vs. bad bugs" lens. As outlined in the preceding sections, clinical interpretation is more informative when it considers these key factors: the ecological balance of the community, the functional pathways present, the metabolic output of those pathways, and the individual patient's context.
Ecological balance: community stability and diversity
Functional pathways: what microbes do, not just which are present
Metabolic output: the compounds produced and their effects
Patient context: immune status, diet, and environment
Key Takeaway
The gut microbiome is a measurable, modifiable part of human physiology. It functions as an ecosystem — and like any ecosystem, its health depends on the balance, diversity, and functional capacity of the community as a whole, not just the presence or absence of individual organisms.
For clinicians, the most useful insight from the microbiome is often functional rather than taxonomic: what the microbial community is producing, how that interacts with the patient’s immune system, gut barrier, and metabolic regulation, and how those outputs may be shifting in the context of that individual’s diet, medications, and clinical picture.
For clinicians, microbiome insights provide an additional lens for understanding systemic regulation, particularly in chronic and complex symptom patterns.
As our understanding of the microbiome deepens, so does the opportunity to use it as a meaningful part of clinical assessment, particularly for patients with chronic or multi-system presentations where traditional markers tell only part of the story.

Fundamentals webinar
If you’d like to join our live event to dive deeper into this register for our Fundamentals webinar.
References:
- Sender R. Fuchs S. & Milo R. Revised Estimates for the Number of Human and Bacteria Cells in the Body.PLoSBiology 14 e1002533 (2016).
- HuttenhowerC. et al. Structure function and diversity of the healthy human microbiome. Nature 486 207–214 (2012).
- Jiang Y. Che L. & Li S. C. Deciphering the personalized functional redundancy hierarchy in the gut microbiome. Microbiome 14 17 (2025).
- Fan Y. & Pedersen O. Gut microbiota in human metabolic health and disease. Nat. Rev.Microbiol. 19 55–71 (2021).
- Lynch S. V. & Pedersen O. The human intestinal microbiome in health and disease. N. Engl. J. Med. 375 2369–2379 (2016).
- Koh A. DeVadderF. Kovatcheva-Datchary P. & Bäckhed F. From Dietary Fiber to Host Physiology: Short-Chain Fatty Acids as Key Bacterial Metabolites. Cell 165 1332–1345 (2016).
- ZhernakovaA. et al. Population-based metagenomics analysis reveals markers for gut microbiome composition and diversity. Science 352 565–569 (2016).
- De Filippis F. et al. Distinct genetic and functional traits of human intestinalPrevotellacopri strains are associated with different habitual diets. Cell Host Microbe 25 444–453 (2019).
- Zhang Z. J. et al.Comprehensive analyses of a large human gutBacteroidales culture collection reveal species- and strain-level diversity and evolution. Cell Host Microbe 32 1853–1867 (2024).
- Tian L. et al. Deciphering functional redundancy in the human microbiome. Nat Commun 11 6217 (2020).
- denBestenG. et al. The role of short-chain fatty acids in the interplay between diet gut microbiota and host energy metabolism. Journal of Lipid Research 54 2325–2340 (2013).
- Morrison D. J. & Preston T. Formation of short chain fatty acids by the gut microbiota and their impact on human metabolism. Gut Microbes 7 189–200 (2016).
- Venkatesh M. et al. Symbiotic Bacterial Metabolites Regulate Gastrointestinal Barrier Function via the Xenobiotic Sensor PXR and Toll-like Receptor 4. Immunity 41 296–310 (2014).
- Honda K. & Littman D. R. The microbiota in adaptive immune homeostasis and disease. Nature 535 75–84 (2016).
- Furusawa Y. et al. Commensal microbe-derived butyrate induces the differentiation of colonic regulatory T cells. Nature 504 446–450 (2013).
- Arpaia N. et al. Metabolites produced by commensal bacteria promote peripheral regulatory T-cell generation. Nature 504 451 (2013).
- MukhopadhyaI. & Louis P. Gut microbiota-derived short-chain fatty acids and their role in human health and disease. Nat Rev Microbiol 23 635–651 (2025).
- Singh V. et al. Butyrate producers “The Sentinel of Gut”: Their intestinal significance with and beyond butyrate and prospective use as microbial therapeutics. Front.Microbiol. 13 (2023).
- Ren T. et al. Indole Propionic Acid Regulates Gut Immunity: Mechanisms of Metabolite-Driven Immunomodulation and Barrier Integrity. JMicrobiolBiotechnol 35 e2503045 (2025).
- Cryan J. F. et al. The Microbiota-Gut-Brain Axis. Physiological Reviews 99 1877–2013 (2019).
- Matsuura M. Structural Modifications of Bacterial Lipopolysaccharide that Facilitate Gram-Negative Bacteria Evasion of Host Innate Immunity. Front. Immunol. 4 (2013).
- ZamyatinaA. & Heine H. Lipopolysaccharide Recognition in the Crossroads of TLR4 and Caspase-4/11 Mediated Inflammatory Pathways. Front. Immunol. 11 (2020).
- Zhu M. et al. C-reactive protein and cancer risk: a pan-cancer study. BMC Med 20 301 (2022).
- RidkerP. M. et al. Relationship of C-reactive protein reduction to cardiovascular event reduction following treatment with canakinumab. The Lancet 391 319–328 (2018).
- Pradhan A. D. Manson J. E. Rifai N. Buring J. E. &RidkerP. M. C-Reactive Protein Interleukin 6 and Risk of Developing Type 2 Diabetes Mellitus. JAMA 286 327–334 (2001).
- d’HennezelE. Abubucker S. Murphy L. O. & Cullen T. W. Total Lipopolysaccharide from the Human Gut Microbiome Silences Toll-Like Receptor Signaling. mSystems 2 e00046-17 (2017).
- Khorsand B. et al. Overrepresentation of Enterobacteriaceae and Escherichia coli is the major gut microbiome signature in Crohn’s disease and ulcerative colitis. Front. Cell. Infect.Microbiol. 12 (2022).
- Thompson K. N. et al. Alterations in the gut microbiome implicate key taxa and metabolic pathways across inflammatory arthritis phenotypes. Science Translational Medicine 15 eabn4722 (2023).
- Desai M. S. et al. A Dietary Fiber-Deprived Gut Microbiota Degrades the Colonic Mucus Barrier and Enhances Pathogen Susceptibility. Cell 167 1339-1353.e21 (2016).
- Zheng J. et al.Noninvasivemicrobiome-based diagnosis of inflammatory bowel disease. Nat Med 30 3555–3567 (2024).
- Qin J. et al. A metagenome-wide association study of gut microbiota in type 2 diabetes. Nature 490 55 (2012).
- Tuomainen M. et al. Associations of serumindolepropionicacid a gut microbiota metabolite with type 2 diabetes and low-grade inflammation in high-risk individuals. Nutrition & Diabetes 8 35 (2018).
- Peron G. et al. A Polyphenol-Rich Diet Increases the Gut Microbiota Metabolite Indole 3-Propionic Acid in Older Adults with Preserved Kidney Function. Molecular Nutrition & Food Research 66 2100349 (2022).
- SpraggeF. et al. Microbiome diversity protects against pathogens by nutrient blocking. Science 382 eadj3502 (2023).
- ByndlossM. X. et al. Microbiota-activated PPAR-γ signaling inhibits dysbiotic Enterobacteriaceae expansion. Science 357 570–575 (2017).
The gut microbiome is
a measurable biological system
The gut microbiome is a dynamic biological system that is essential to normal human physiology, influencing immune regulation, gut barrier integrity, metabolism, and systemic signaling1.
It is a clinically relevant biological system with meaningful implications for complex and multi-system presentations.

The gut microbiome is composed of diverse microbial communities
The gut microbiome is a diverse community of microorganisms that actively shape gut function through metabolism, competition, and interactions with the immune system and gut lining. This community includes:
Bacteria

Archaea

Viruses

Fungi
Microbial interactions are shaped by balance, not fixed labels
The nature of these interactions is not fixed, it depends on the gut environment and overall ecological balance. These interactions generally fall into four categories:
COMMENSAL
Present without measurable benefit or harm to the host.
MUTUALISTIC
Contributes positively to metabolism, immune regulation or barrier integrity.
OPPORTUNISTIC
Typically neutral, but may cause harm when ecological balance shifts.
PHATHOGENIC
Capable of causing disease or disrupting normal function.
Microbes convert fuel into compounds that influence health
Gut microbes feed on available substrates including dietary fibre, proteins and host-derived compounds and convert them into metabolites that interact with body systems.1,2 What they produce depends on which microbes are present, the functional pathways they carry, and the fuel sources available to them.

There’s more to explore
Read the full guide to microbiome structure, function and clinical interpretation.
The microbiome influences health through four key pathways
Microbes influence human physiology through the compounds they produce and the signals they generate. These microbial metabolites interact with immune pathways, support gut barrier integrity, and contribute to broader metabolic regulation.
Metabolism
Microbial metabolites influence energy use, lipid processing and systemic metabolic balance
Immune regulation
The gut microbiome helps regulate immune responses and maintain immune balance
Gut barrier function
Microbial activity supports epithelial integrity.
Gut–brain & systemic signalling
Microbial compounds contribute to systemic signaling by influencing immune, hormonal, neural pathways beyond the gut, including gut–brain communication
The microbiome functions as part of human biology — not separate from it.
It’s not enough to know which microbes are present, you need to know what the ecosystem is doing
Microbiome species vary widely between individuals, yet different species can produce the same essential metabolites. Two people with very different microbial profiles may share comparable functional output.
This is why clinical insight increasingly focuses on metabolic activity, such as butyrate production, rather than species detection alone.

Microbiome insight adds a systems-level lens to clinical care.
The microbiome interacts with multiple biological systems simultaneously, it can provide additional interpretive insight in chronic and complex cases.
In multi-system presentations not fully explained by traditional markers, understanding microbial function adds a broader systems-level perspective.
In multi-system presentations not fully explained by traditional markers, understanding microbial function adds a broader systems-level perspective.
In multi-system presentations not fully explained by traditional markers, understanding microbial function adds a broader systems-level perspective.
Ecological balance: community stability and diversity
Functional pathways: what microbes do, not just which are present
Metabolic output: the compounds produced and their effects
Patient context: immune status, diet, and environment
Key Takeaway
The human microbiome is a measurable biological system that functions as part of normal human physiology. Balance and functional output are more clinically meaningful than species detection. Microbiome composition varies significantly between individuals, and microbiome insight adds particular value in chronic and complex presentations where traditional markers don’t tell the full story.

Lunch and learn series
Build a practical foundation in microbiome science with our new 90-minute online sessions - from what the microbiome is and how we measure it, to what it means in clinical practice.
References:
- Fan Y. & Pedersen O. Gut microbiota in human metabolic health and disease. Nat. Rev. Microbiol. 19 55–71 (2021).
- Koh A. De Vadder F. Kovatcheva-Datchary P. & Bäckhed F. From Dietary Fiber to Host Physiology: Short-Chain Fatty Acids as Key Bacterial Metabolites. Cell 165 1332–1345 (2016).
- Lynch S. V. & Pedersen O. The human intestinal microbiome in health and disease. N. Engl. J. Med. 375 2369–2379 (2016).
- Huttenhower C. et al. Structure function and diversity of the healthy human microbiome. Nature 486 207–214 (2012).
- Jiang Y. Che L. & Li S. C. Deciphering the personalized functional redundancy hierarchy in the gut microbiome. Microbiome 14 17 (2025).
- Tian L. et al. Deciphering functional redundancy in the human microbiome. Nat Commun 11 6217 (2020).
Most tests only measure a partial view of that ecosystem
Species-level detection
Measures the presence or absence of individual organisms in isolation - no diversity data, no functional insight, no understanding of how the community behaves as a whole.
Ecosystem-level assessment
Captures the full community picture: diversity, relative abundance, functional capacity, and the physiological conditions that shape how the microbiome actually functions.
Partial testing can’t reliably answer critical questions
In clinical practice, microbiome testing is rarely about detection alone.
The goal is interpretation: understanding how microbial ecology may be influencing:

Chronic symptoms

Inflammation
Gut barrier integrity

Metabolic signalling
Interpretation requires context
A partial view of the microbiome may detect something, but it can’t reliably answer the more clinically meaningful questions
How does this organism’s abundance compare to the overall ecosystem? How does this organism’s abundance compare to the overall ecosystem?
Is the ecosystem resilient or vulnerable to instability?
Is functional capacity reduced?
Is it contributing to an anti-inflammatory or pro-inflammatory state?
Microbiome balance emerges from the whole system; targeted tests are inherently limited in what they can explain.
Healthy gut microbial communities are characterised by high taxa diversity, high microbial gene richness, and a stable functional core, properties that cannot be captured by targeted detection methods alone.¹

Testing technologies vary in what they can measure and reveal
Microbiome testing has progressed through several technological stages. Each has improved capability, but not all are designed to assess ecosystem-level balance. Understanding these differences helps clinicians choose appropriate tools and interpret results correctly.
Culture-Based Testing Useful for pathogen detection, not for ecosystem assessment. Culture remains valuable for identifying certain infectious organisms and guiding antimicrobial therapy2. However: Many gut organisms cannot be cultured using standard laboratory techniques. Culture favours organisms that grow well in-vitro, not necessarily those most relevant in-vivo. It provides no information about diversity or ecological relationships.
Highly sensitive - but only for selected targets. PCR-based testing is extremely useful when there is a specific clinical hypothesis (e.g., presence of potential pathogens such as C. difficile, Giardia).2 However:2 You can only detect what you test for. It does not provide ecosystem-level composition. It does not assess diversity or resilience. It does not evaluate functional capacity. It cannot identify unexpected or emerging organisms. PCR answers specific questions well, however it is not designed to assess ecosystem balance.
Broader view, but limited resolution and no direct functional insight. 16S rRNA gene sequencing (16S) allows a broader survey of bacterial communities without culture. However, 16S rRNA sequencing is an amplicon-based method. It targets and amplifies a small region of the 16S ribosomal RNA gene, which is only present in bacteria and Archaea. This creates several clinically relevant limitations: Often limited to genus-level resolution, with species-level identification carrying a high rate of false positives³ ⁴ Inability to reliably distinguish clinically important species within the same genus. No detection of fungi or protists and 16S rRNA targets often miss Archaea³ ⁴ It cannot identify novel or uncharacterised organisms No direct measurement of microbial functional genes or pathways. Research directly comparing the two approaches confirms that 16S detects only part of the gut microbiota community revealed by shotgun sequencing, and that less abundant — but biologically meaningful, taxa are largely invisible to 16S methods.⁴ 16S can reveal broad trends, but it does not provide the resolution or functional depth required for high-confidence clinical interpretation.
Whole-community, species-level, function-aware measurement. Shotgun metagenomics sequences all DNA in a sample. This enables clinicians to assess: Composition: species and even strain-level identification of microorganisms Breadth: bacteria, fungi, Aarchaea, protists and other microbial DNA Discovery: detection of previously uncharacterised organisms Function: microbial genes and metabolic pathways Studies demonstrate that shotgun metagenomicwhole genome sequencing has multiple advantages over 16S amplicon methods, including enhanced detection of bacterial species, increased detection of diversity, and direct assessment of increased predictionfunctional of genes.5 6
The critical shift
Metagenomics enables ecosystem-level assessment. Because it captures the full genetic content of the community. ⁵ Not just selected fragments
Comparison of microbiome testing methods
The table below summarises how common microbiome testing approaches differ in scope, resolution, and suitability for assessing ecosystem-level balance.
Why functional capacity matters
In an ecological model, clinical impact is determined not just by which organisms are present, but by what the ecosystem can do.
This is called the Functional capacity. These functions are distributed across multiple organisms that share metabolic pathways.

Clinically relevant examples include
Short-chain fatty acid (SCFA) production (e.g. butyrate)
SCFAs are produced through bacterial fermentation of dietary fibre and play key roles in gut barrier integrity, immune modulation, and inflammation control. Reduced SCFA-producing capacity has been linked to increased intestinal permeability and systemic inflammatory burden.⁷ ⁸
Pro-inflammatory LPS signalling potential
LPS produced by Gram-negative bacteria triggers innate immune activation. Dysbiosis, with reduced diversity and overgrowth of pro-inflammatory LPS-producing organisms, shifts the microbiome towards a pro-inflammatory state, contributing to low-grade systemic inflammation and chronic disease risk.⁹ ¹⁰
Mucin degradation activity
Mucin-degrading organisms including Akkermansia muciniphila and Bacteroides species can promote mucus production when at optimal levels but can deplete the mucus layer at high levels. Excessive mucus degradation can compromise mucosal integrity and increase immune activation. ¹¹ ¹²
Protein fermentation by-products
Fermentation of undigested protein in the distal colon produces metabolites including trimethylamine, hydrogen sulphide, branched-chain amino acids, ammonia and phenolic compounds, some of which drive intestinal inflammation and may contribute to systemic toxic load at elevated concentrations.
Without functional information
Clinicians are left interpreting composition alone which often fails to explain chronic symptoms, relapse cycles, or systemic inflammatory burden.
Whole-ecosystem testing changes the clinical questions
When clinicians move from targeted detection to whole-community measurement, the clinical questions evolve. These are the questions that matter in complex, chronic presentations. Research linking gut dysbiosis to over 117 gastrointestinal and extra-gastrointestinal diseases underscore why understanding the ecosystem state, not just species presence, is clinically essential.¹³

These are the questions that matter in complex, chronic presentations. Research linking gut dysbiosis to over 117 gastrointestinal and extra-gastrointestinal diseases underscore why understanding the ecosystem state, not just species presence, is clinically essential.¹³
Clinical-grade testing requires more than technology
Whole-community sequencing is a necessary foundation, but clinical application requires more.
For metagenomics to be clinically useful, it must be delivered through validated and accredited processes. Clinical-grade testing requires:

Validated sample collection and preservation
The microbiome changes rapidly once a sample is produced. Without robust preservation, results can be distorted by microbial growth, degradation, or DNA fragmentation.

Accredited laboratory standards (e.g., ISO 15189)
Clinical-grade testing requires operation to medical laboratory standards, including quality systems, traceability, and analytical validation.

High-quality bioinformatics pipelines
Metagenomic data is only as useful as the computational system interpreting it. Low-quality bioinformatics increases false positives, misclassification, and missing data.

Evidence-based interpretation frameworks
Results must be aligned with reproducible evidence in humans and presented in a clinically usable format.
Metagenomics is only clinically meaningful when results are accurate, reproducible, and interpretable.
A Practical Summary for Clinicians
Microbiome balance is an ecosystem property. It cannot be accurately assessed through partial or targeted testing alone.
Culture, PCR, and 16S methods can answer specific questions but they do not provide whole-ecosystem visibility.
If the clinical goal is ecosystem-level understanding, whole-community metagenomics is required.
And if the goal is actionable interpretation, the metagenomic assessments must be delivered through validated, clinical-grade systems.

A healthy gut microbiome requires a balanced ecosystem
Like any ecosystem, a healthy gut microbiome is a balanced one. Evaluating that balance cannot be reduced to a list of well-known species. It emerges from complex microbial interactions across the whole ecosystem, from diversity to environment

Diversity

Relative abundance

Functional capacity

Physiological environment
Most tests only measure a partial view of that ecosystem
Most testing technologies measure only fragments of this ecosystem, evaluating a partial list of well-known species and attempt to infer "balance" from that partial view. If the clinical question is ecosystem balance, the measurement must reflect the ecosystem.
Species-level detection
Measures the presence or absence of individual organisms in isolation - no diversity data, no functional insight, no understanding of how the community behaves as a whole.
Whole ecosystem assessment
Captures the full community picture: diversity, relative abundance, functional capacity, and the physiological conditions that shape how the microbiome actually functions.
Looking for the deep dive?
Read the full article: Measuring the microbiome as an ecosystem
Partial testing can’t reliability answer
critical clinical questions
How does this organism’s abundance compare to the overall ecosystem?
Is the ecosystem resilient or vulnerable to instability? ²³
Is functional capacity reduced?
Is it contributing to an anti-inflammatory or pro-inflammatory state?

Ecosystem-level assessment unlocks critical patient insights.
In practice, microbiome testing is about more than detecting which species are present. The goal is interpretation: understanding how the microbiome may be influencing symptoms, inflammation, gut barrier function, and metabolic signalling

Chronic symptoms

Inflammatory resistance
Gut barrier integrity

Metabolic signalling
Testing technologies vary in what they can measure and reveal
Culture
Useful for pathogen detection - not ecosystem assessment.
- Culture can identify certain infectious organisms.
- Identifies organisms that grow in lab conditions
- Misses many microbes that cannot be cultured
- Provides no insight into diversity or function¹
Targeted PCR / qPCR
Highly sensitive, but only for selected targets.
- Excellent at confirming specific organisms
- Cannot assess broader community balance
- Does not detect organisms outside the selected panel.²
16S rRNA gene sequencing
Broader view — but limited resolution and no direct functional insight.
- Surveys bacterial communities without culture
- Often limited to genus-level resolution
- Does not directly measure functional genes or pathways⁴
Shotgun Metagenomics
Whole-community, species-level, function-aware measurement.
- Sequences all DNA in the sample
- Detects bacteria, fungi, archaea and other microbes
- Provides species-level identification
- Enables functional gene and pathway profiling⁵
Looking for the deep dive?
Read the full article: Measuring the microbiome as an ecosystem
The critical shift
Metagenomics enables ecosystem-level assessment. Because it captures the full genetic content of the community. ⁵ Not just selected fragments
Ecosystem-level assessment reveals functional capacity
Clinical impact is determined not just by which organisms are present, but by what the ecosystem is functionally doing within the body. We call this functional capacity.
Examples include
- Short-chain fatty acid production (e.g. butyrate), which supports immune regulation and barrier integrity.⁵
- Lipopolysaccharide (LPS) signalling potential from Gram-negative organisms, associated with inflammatory activation.⁸
- Mechanisms influencing gut barrier permeability.

Without insights into the functional capacity of the microbiome, clinicians are left interpreting microbial composition alone, which often fails to explain chronic symptoms or relapsing presentation.
Whole-ecosystem testing supports more informed clinical decision-making
Whole-ecosystem testing fundamentally changes how clinicians think about patient symptoms. It moves the clinical question from “what organism is present?” to “how is this ecosystem functioning, and what is it driving?” This is where clinical-grade testing comes in.

Clinical-grade testing requires more than technology
Whole-community sequencing is a necessary foundation, but clinical application requires more.
Metagenomics is only clinically meaningful when results are accurate, reproducible, and interpretable. For that, the technology has to be embedded in validated, accredited systems. Technology alone doesn't deliver clarity. Integrated systems do.
Validated sample collection and preservation
Accredited laboratory standards (e.g. ISO 15189)
High-quality bioinformatics pipelines⁷
Evidence-based interpretation frameworks
The most accurate picture requires the right combination of technologies
No single method answers every clinical question.
To deliver true ecosystem insight, testing must integrate:
Shotgun metagenomics for full community and functional capacity⁵
Validated Gut health markers to assess gut barrier function and inflammation
PCR for targeted pathogen confirmation

Practical summary
Microbiome balance is an ecosystem property within the gut environment. ¹²
- Partial testing measures fragments, not systems.
- Functional capacity determines clinical impact. ⁵
- Ecosystem-level understanding requires whole-community measurement.
- Clinical-grade clarity requires validated systems, not just sequencing.
- If the goal is confident, actionable insights, then the whole ecosystem must be

Costello EK et al. The application of ecological theory toward an understanding of the human microbiome. Science. 2012.
Coyte KZ et al. The ecology of the microbiome: networks, competition, and stability. Science. 2015.
Lozupone CA et al. Diversity, stability and resilience of the human gut microbiota. Nature. 2012.
Jovel J et al. Characterization of the gut microbiome using 16S or shotgun metagenomics. Front Microbiol. 2016.
Human Microbiome Project Consortium. Structure, function and diversity of the healthy human microbiome. Nature. 2012.
Ranjan R et al. Analysis of the microbiome: Advantages of whole genome shotgun versus 16S amplicon sequencing. BBRC. 2016.
Quince C et al. Shotgun metagenomics, from sampling to analysis. Nat Biotechnol. 2017.
Zhernakova A et al. Population based metagenomics analysis reveals markers for gut microbiome composition and diversity. Science. 2016.







